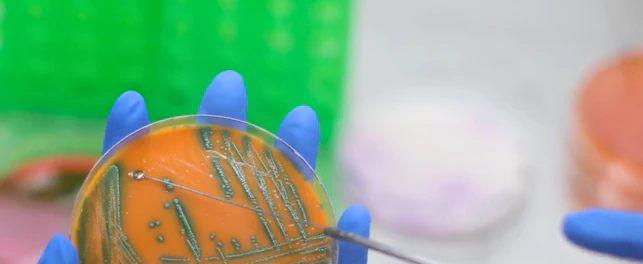
sgs

SGS, líder global en pruebas, inspección y certificación, ha lanzado una nueva plataforma global de inteligencia alimentaria diseñada para ayudar a la industria a anticipar riesgos y fortalecer la seguridad alimentaria a lo largo de toda la cadena de valor.
La solución combina datos provenientes de análisis de alimentos, información regulatoria y capacidades avanzadas de análisis predictivo para ofrecer a las empresas una visión más clara sobre los riesgos emergentes que pueden afectar la calidad, inocuidad y cumplimiento de sus productos.
Un cambio de enfoque: de la reacción a la anticipación
Tradicionalmente, la industria alimentaria ha gestionado los riesgos de forma reactiva, basándose en resultados de laboratorio posteriores a la producción.
Sin embargo, el crecimiento del comercio internacional y el aumento de las exigencias regulatorias han hecho necesario adoptar un enfoque más proactivo.
Hoy, un incumplimiento en aspectos como residuos de pesticidas en alimentos o límites regulatorios como los LMR alimentos puede derivar en:
- Rechazos en exportación
- Pérdidas económicas
- Interrupciones operativas
En este contexto, la nueva plataforma de SGS permite identificar patrones y tendencias antes de que se conviertan en incidentes críticos.
Integración de datos y análisis de alimentos
SGS Food Nexus se lanza con dos soluciones de productos complementarios que abordan todo el espectro de necesidades de seguridad alimentaria e inteligencia regulatoria.
Además la plataforma integra múltiples fuentes de información, incluyendo:
- Resultados de laboratorio de alimentos
- Tendencias de contaminantes
- Cambios regulatorios internacionales
- Datos históricos de la industria
A pesar de este enfoque basado en datos, el laboratorio de alimentos continúa siendo un elemento clave.
El análisis de alimentos sigue siendo la herramienta fundamental para validar la calidad y la inocuidad real de los productos.

Impacto en la industria alimentaria
La adopción de soluciones de inteligencia alimentaria permite a las empresas:
- Anticipar riesgos microbiológicos y químicos
- Optimizar sus programas de control
- Mejorar la toma de decisiones
- Asegurar el cumplimiento normativo
Esto resulta especialmente relevante para empresas que realizan análisis de alimentos para exportación, donde los estándares son cada vez más exigentes.
Una evolución en la gestión de riesgos
La plataforma refleja una tendencia clara en la industria: La evolución hacia modelos de gestión basados en datos, predicción y validación científica.
SGS continúa apoyando a la industria alimentaria mediante soluciones que combinan tecnología, conocimiento técnico y capacidades de laboratorio para mejorar la seguridad alimentaria a nivel global.
FAQ - Preguntas frecuentes
Acerca de SGS
SGS es la empresa líder mundial en servicios de ensayos, inspección y certificación. Operamos una red de más de 2,500 laboratorios y oficinas comerciales en 115 países, respaldados por un equipo de 99,500 profesionales. Con más de 145 años de excelencia en el servicio, combinamos la precisión y exactitud que caracterizan a las empresas suizas para ayudar a las organizaciones a alcanzar los más altos estándares de calidad, cumplimiento y sostenibilidad.
Nuestra promesa de marca – when you need to be sure, resalta nuestro compromiso con la confianza, integridad y seguridad, permitiendo que las empresas prosperen con confianza. Brindamos con orgullo nuestros servicios especializados bajo el nombre de SGS y marcas confiables como Brightsight, Bluesign, Maine Pointe y Nutrasource.
SGS cotiza en la Bolsa SIX Swiss Exchange bajo el símbolo SGSN (ISIN CH1256740924, Reuters SGSN.S, Bloomberg SGSN:SW).